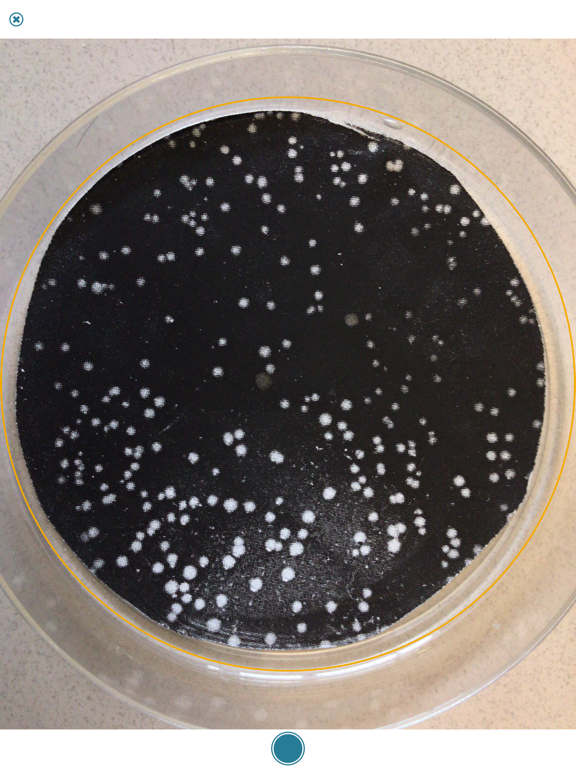
App screenshot

Promega Colony Counter
Promega Colony Counter Summary
Promega Colony Counter is a mobile iOS app in Tools by Promega Corporation. Released in Mar 2013 (12 years ago). It has 18 ratings with a 2.94★ (poor) average. Based on AppGoblin estimates, it reaches roughly 73 monthly active users . Store metadata: updated Oct 3, 2016.
Store info: Last updated on App Store on Oct 3, 2016 .
2.94★
Ratings: 18
Screenshots

App Description
Is the tedium of squinting over agar plates counting bacterial colonies getting to you? Take the plates out of the lab! No, not literally. Snap a picture with your phone and you can make counting an out-of-lab experience. The Colony Counter app gives you a count estimate you can then manually refine. Save single plates or sets for later comparison. Happy Counting!
The fine print: Our app was tested with JM109 High Efficiency Competent Cells grown up in 50ml LB Medium; other plate and colony combos weren’t tested. In other words, white on yellow; that’s it.